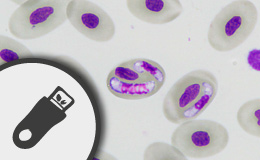

Z7_NQ5E12C0LG5PD0664OOU4NNSJ6
Inglés UdeA - Cabezote - WCV(JSR 286)
Access key
Alt + 1 - Home
Alt + 2 - About Us
Alt + 3 3 - Staff Directory
Alt + 4 - Search
Alt + 5 - Academic Exchange
Alt + 6 - Research groups and centers
Z7_NQ5E12C0LG5PD0664OOU4NNSB4
Index Signpost
VI International Conference on Malaria
Z7_NQ5E12C0LG5PD0664OOU4NNI43
Portal U de A - Visor de Contenido - WCV(JSR 286)
Z7_NQ5E12C0LG5PD0664OOU4NNSB6
UdeA - Rotador Interno (Home2) - WCV(JSR 286)
Z7_NQ5E12C0LG5PD0664OOU4NNSB5
UdeA - Título de sección - WCV(JSR 286)
Conoce la UdeA
Z7_NQ5E12C0LG5PD0664OOU4NNSB7
Portal U de A - Destacados Home 2 - WCV(JSR 286)
Z7_NQ5E12C0LG5PD0664OOU4NNSR4
UdeA - Título de sección - WCV(JSR 286)
También te puede interesar
Z7_NQ5E12C0LG5PD0664OOU4NNSR6
Listado Home 2
10 resultados
Anterior | Siguiente
Z7_NQ5E12C0LG5PD0664OOU4NNSR5